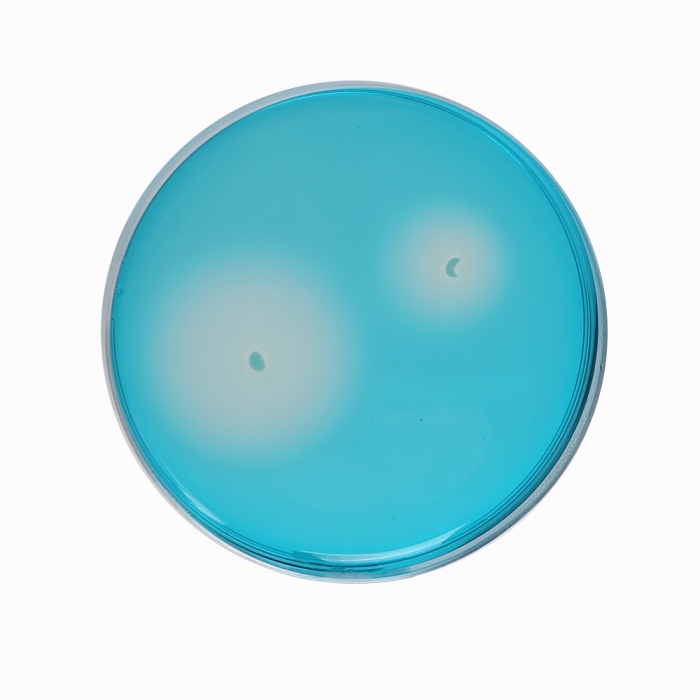

Your enquiry has been submitted
Semisolid IMRV Medium Base
Semisolid IMRV Medium Base is used for the simultaneous enrichment as well as isolation of motile Salmonella from other competitive organisms
Composition**
| Ingredients | Gms/Litre |
|---|---|
| Casein enzymic hydrolysate | 13.500 |
| Peptic digest of animal tissue | 13.500 |
| Saccharose | 7.500 |
| Lactose | 0.500 |
| Ammonium ferric sulphate | 0.200 |
| Sodium thiosulphate | 0.800 |
| Potassium dihydrogen phosphate | 1.470 |
| Magnesium chloride, anhydrous | 10.910 |
| Malachite green | 0.037 |
| Bromo cresol purple | 0.080 |
| Agar | 2.700 |
Final pH (at 25°C): 5.5±0.2
**Formula adjusted, standardized to suit performance parameters
Directions
Suspend 51.2 grams in 1000 ml distilled water. Heat with stirring to boiling to dissolve the medium completely. DO NOT AUTOCLAVE / DO NOT OVERHEAT. Cool to 45°C and aseptically add rehydrated contents of 1 vial of IMRV/RV Selective Supplement (FD193). Mix well and pour into sterile Petri plates.
Note: The motility of Salmonellas can be drastically reduced when the agar surface becomes too dry. Hence the plates should be well dried before use. If visible moisture occurs on the lid of the plates or the surface of agar, it must be removed. While incubation, incubate the plates aerobically in an upright position for no longer than 24 hours at 42°C.
Principle And Interpretation
Semisolid IMRV Medium Base is used for simultaneous enrichment and isolation of motile Salmonella from food and environmental samples. It is diagnostic medium distinguishing motile Salmonella from non motile forms (1, 2). Also Salmonella can be identified from a mixed culture of different gram negative organisms. These media detects more Salmonella positive samples than the routinely used enrichment procedures (3,4,5). Addition of Novobiocin as a supplement and malachite green in the medium selectively inhibits most gram positive organisms. Salmonella generally survives a little high osmotic pressure (due to MgCl2 in the medium), grows at slightly low pH and are resistant to malachite green compared to other bacteria. Saccharose, lactose and bromocresol purple differentiates Salmonella from lactose and sucrose fermenting organisms. Ammonium ferric sulphate and sodium thiosulphate are indicators of H2S production. Thiosulphate is reduced to hydrogen sulphide by several species of bacteria and H2S combines with ferric ions to produce the insoluble black precipitate of ferrous sulphide as indicated by formation of grayish black colour at the centre of the colony.
Casein enzymic hydrolysate and peptic digest of animal tissue, provide the nitrogenous and carbonaceous substances and other essential growth nutrients. Phosphate gives good buffering capacity to the medium. Addition of novobiocin as a supplement (FD193) and malachite green in the medium selectively inhibits most gram-positive organisms. Sodium chloride maintains the osmotic equilibrium of the media. All these factors make the medium selective for the isolation of Salmonella. This medium enriches Salmonella and the semi-solid nature of the medium helps to differentiate the motile Salmonella from non-motile ones.
Quality Control
Appearance: Light yellow to blue homogeneous free flowing powder
Gelling: Semisolid, comparable with 0.27% Agar gel.
Colour and Clarity of prepared medium: Dark green coloured clear semisolid gel forms in Petri plates
Reaction: Reaction of 5.12% w/v aqueous solution at 25°C. pH : 5.5±0.2
pH: 5.30-5.70
Cultural Response
M1427: Cultural characteristics observed after an incubation at 42-43°C for 18-24 hours with added IMRV/RV Selective Supplement (FD193), when one drop of culture is inoculated in the centre of the medium plate.(Motility is checked by inoculating a drop of culture in the centre of the medium plate).
| Organism | Inoculum (CFU) | Growth | Motility |
|---|---|---|---|
| Citrobacter freundii ATCC 8090 | >=103 | inhibited | |
| Pseudomonas aeruginosa ATCC 9027 | >=103 | inhibited | |
| Salmonella Typhimurium ATCC 14028 | 50-100 | good | positive, development of purple halos of growth originating from the inoculation spot. |
Storage and Shelf Life
Store below 30°C in tightly closed container and the prepared medium at 2-8°C. Use before expiry date on the label.
Reference
- Vander Zee H, and Van Netten P. 1992 Proc. Symp. "Salmonella and Salmonellosis". Ploufragan ; 69.
- Ruzickova, V; Karpiskova, R. and Pakrova, E. 1996. Vet Med. Praha. 41 (9): 283-288.
- DeSmedt J. M., Bolderjik R. F., 1987, J. Food Prot.; 50: 658-661.
- DeZutte et al, 1991, Int. J. Food Microbiol., 13:11
- DeSmedt J. M. et al, 1991, Int. J. Food Microbiol. 13:301
| Product Name | Semisolid IMRV Medium Base |
|---|---|
| SKU | M1427 |
| Product Type | Regular |
| Physical Form | Powder |
| Origin | Animal |
| Packaging type | HDPE |
| References | 1. Vander Zee H, and Van Netten P. 1992 Proc. Symp. “Salmonella and Salmonellosis”. Ploufragan ; 69. |
| Customized Product Available | No |